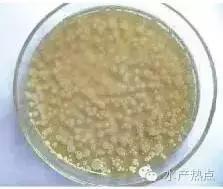
水产养殖芽孢杆菌培养方法,水产养殖芽孢杆菌多久有效果

1、芽孢杆菌作为一种简易的细菌(真细菌),是土壤中的优势种群,能强烈地分解碳系、氮系、磷系、硫系污染物,分解蛋白质和复杂多糖,对水溶性有机物分解也有重要的作用,同时可以与养殖环境中的有害藻类及水产致病菌竞争,形成优势种群,抑制有害藻类及水产致病菌。由于它的特性与功能优于光合细菌而有望成为光和细菌的替代品,已成为当前国际净水界的研究热点。

2、芽孢杆菌特点
芽孢杆菌(Baciuus)为革兰氏染色阳性,是普遍存在的一类好氧性细菌,多属芽孢杆菌属。在生长后期能形成芽孢(内生孢子)的杆菌或球菌。芽孢是休眠体,不是繁殖体。尽人多数足一个菌体仅肜成一个芽孢。芽孢位于菌体内,山核心、皮层、芽孢壳和外壁组成。核心是芽孢的原生质休,内含DNA、RNA、可能与DNA相联系的特异芽孢蛋白质以及合成蛋白质和产生能量的系统。此外,还有大量的吡啶二羧酸钙布满整个芽孢。皮层处于核心和芽孢壳之间,舍有丰富的肽聚糖。芽孢壳主要由蛋白质组成,此外,还有少量的碳水化合物和类脂类,可能还有大量的磷。最外层是外壁,其主要成分是蛋白质、一定量的葡萄糖和类脂。

芽孢杆菌在制剂中以内生孢子的形式存在,孢子进进肠道后,在肠道上部能迅速复活并分泌活性很强的蛋白酶、脂肪酶、淀粉酶,有助于降解植物性饲料中某些复杂的碳水化合物,拮抗肠道内的氧气,造成厌氧环境。肠道原籍上风菌大多属厌氧菌,而有害菌和外来菌多为需氧菌,从而有利于维持肠道生态平衡。该类菌无毒性,能分泌出活性强的蛋白酶等多种酶类,在其生命过程中又能以孢子体形式存在,具有耐高温、耐盐碱、耐挤压、饲料加工对其损伤小等特性,易于生产和保存,作为饲料微生态添加剂和水体微生态调控剂都有广阔远景。

3、芽孢杆菌种类
目前可利用的芽孢杆菌有:枯草芽孢杆菌凝结芽孢杆菌 缓慢芽孢杆菌 地衣芽孢杆菌 短小芽孢杆菌 蜡样芽孢杆菌 环状芽孢杆菌 巨大芽孢杆菌 坚强芽孢杆菌 东洋芽孢杆菌 纳豆芽孢杆菌 芽孢乳杆菌 丁酸梭等。

4、芽孢杆菌在水产养殖中的作用
(1)占位效应
正常微生物通过占位效心,即竞争性粘附位点来阻止病原菌附着。芽孢杆菌进入动物胃肠道后,通过生物夺氧作用在生长繁值过程中消耗肠内过量的气体,造成厌氧状态,而抑制自害菌的繁殖。并且,芽孢杆菌在生长繁殖过程中可产生细菌素、有机酸等物质,改变肠内微生态环境,形成小利于有害菌牛长的环境。

(2)产生有益代谢产物
a.合成多种酶类:苷孢杆菌具有很强的蛋白酶、脂肪酶、淀粉酶、精化酶活性,可降解饲料中的某些抗营养因子,提高饲料转化率可达8%以上。在肠道内繁殖,还可产生各种营养物质,如维生素、氨基酸、未知生长因子等,参与机体的新陈代谢,促进动物生长。
b.产生有机酸:芽孢杆菌进入动物肠道繁殖能够产尘乙酸、内酸和丁酸等挥发性脂肪酸,降低肠道pH值,抑制病原菌的生长,激活酸性蛋白酶活性。
c.产生抗菌物质:芽孢杆十菌在动物肠道内产生大量细菌素,如杆菌肽、多粘菌素、线性环多肽复合物等,可有效地抑制和杀灭进入体内的大肠杆菌和沙门氏菌等。
d.清除有害物质:芽孢杆菌产生的氯基氧化酶及分解硫化氢的酶类,可降低血液及水体中氮氦、亚硝酸盐、硫化氢的浓度,从而净化养殖水环境。
文章来源:一路凯哥 作者:朱凯宇